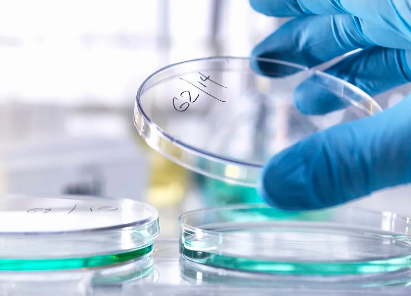
image.png

國內(nèi)哪家干細胞醫(yī)院知名度最高?
2024-10-25 11:34:24 來源: 小編 咨詢醫(yī)生
本文將深入分析我國干細胞治療領(lǐng)域的發(fā)展現(xiàn)狀,以及哪家干細胞醫(yī)院在業(yè)界具有最高的知名度。
干細胞治療作為一種前沿的生物技術(shù),近年來在我國得到了廣泛關(guān)注。在國內(nèi),多家干細胞醫(yī)院在臨床應(yīng)用和研究方面取得了顯著成果。那么,哪家干細胞醫(yī)院知名度最高呢?下面我們來一探究竟。
首先,我們需要了解干細胞治療的基本概念。干細胞是一種具有自我更新和分化潛能的細胞,可以分化成各種類型的細胞。干細胞治療就是利用干細胞的這種特性,修復(fù)受損傷的器官或組織,從而達到治療疾病的目的。
在我國,干細胞治療領(lǐng)域的發(fā)展可以分為三個階段:
1.起步階段:20世紀90年代,我國開始關(guān)注干細胞研究,并取得了一定的成果。
2.發(fā)展階段:21世紀初,我國干細胞治療研究逐漸走向成熟,多家醫(yī)院開始開展干細胞治療項目。
3.提升階段:近年來,我國干細胞治療技術(shù)取得了重大突破,臨床應(yīng)用范圍不斷擴大。
那么,哪家干細胞醫(yī)院知名度最高呢?
在眾多干細胞醫(yī)院中,北京協(xié)和醫(yī)院無疑具有極高的知名度。北京協(xié)和醫(yī)院是我國最早的干細胞治療研究基地之一,擁有豐富的臨床經(jīng)驗和先進的技術(shù)設(shè)備。在干細胞治療心臟病、神經(jīng)系統(tǒng)疾病、血液病等領(lǐng)域取得了顯著成果。
此外,以下幾家干細胞醫(yī)院也在業(yè)界具有較高的知名度:
1.上海交通大學(xué)醫(yī)學(xué)院附屬仁濟醫(yī)院:在干細胞治療肝臟疾病、腎臟疾病等領(lǐng)域有顯著成果。
2.廣州醫(yī)科大學(xué)附屬第一醫(yī)院:在干細胞治療呼吸系統(tǒng)疾病、免疫系統(tǒng)疾病等領(lǐng)域有突出表現(xiàn)。
3.浙江大學(xué)醫(yī)學(xué)院附屬第一醫(yī)院:在干細胞治療神經(jīng)系統(tǒng)疾病、消化系統(tǒng)疾病等領(lǐng)域有豐富經(jīng)驗。
總之,北京協(xié)和醫(yī)院在干細胞治療領(lǐng)域的知名度最高,但其他幾家醫(yī)院也在各自領(lǐng)域取得了令人矚目的成果。隨著我國干細胞治療技術(shù)的不斷發(fā)展,未來將有更多優(yōu)秀的干細胞醫(yī)院崛起,為更多患者帶來希望。
- 2024-10-20造血干細胞移植哪家醫(yī)院好?如何提高移植成功率?
- 2024-11-16干細胞腎病治療醫(yī)院哪家好,治療效果如何
- 2024-10-16腎病干細胞治療醫(yī)院排名榜,哪家醫(yī)院口碑好?
- 2024-11-03中國哪家干細胞醫(yī)院最具專業(yè)實力?
- 2024-11-05廣東牙髓干細胞醫(yī)院哪家口碑最佳?
- 2024-11-26江蘇人體干細胞移植機構(gòu)哪里好,如何選擇專業(yè)機構(gòu)
- 2024-10-09治痛風(fēng)哪種干細胞療法更有效?效果真的可靠嗎?
- 2024-10-11干細胞治療鼻炎真的有效嗎?有沒有臨床數(shù)據(jù)支持?
- 2024-08-08干細胞的用途有哪些,干細胞的價值和作用
- 2024-08-23干細胞除皺多久見效果,療效與風(fēng)險全解讀
- 2024-10-11干細胞儲存的費用是多少?如何確保儲存的安全可靠?
- 2024-08-07干細胞免疫療法,干細胞免疫療法可以治療哪些病癥
- 2024-09-02上游干細胞存儲中游機構(gòu),細胞存儲公司排名前十
- 2024-07-21干細胞有什么作用,干細胞作用效果怎么樣
- 2024-09-14干細胞治帕金森費用多少,附原理效果
- 2024-10-11干細胞抗衰老真的靠譜嗎?哪些人群適合做?
- 2024-10-05 延安干細胞存儲公司哪家強?如何選擇正規(guī)可靠的公司?
- 2024-10-02嘉興人體干細胞有哪些作用,應(yīng)用前景如何
